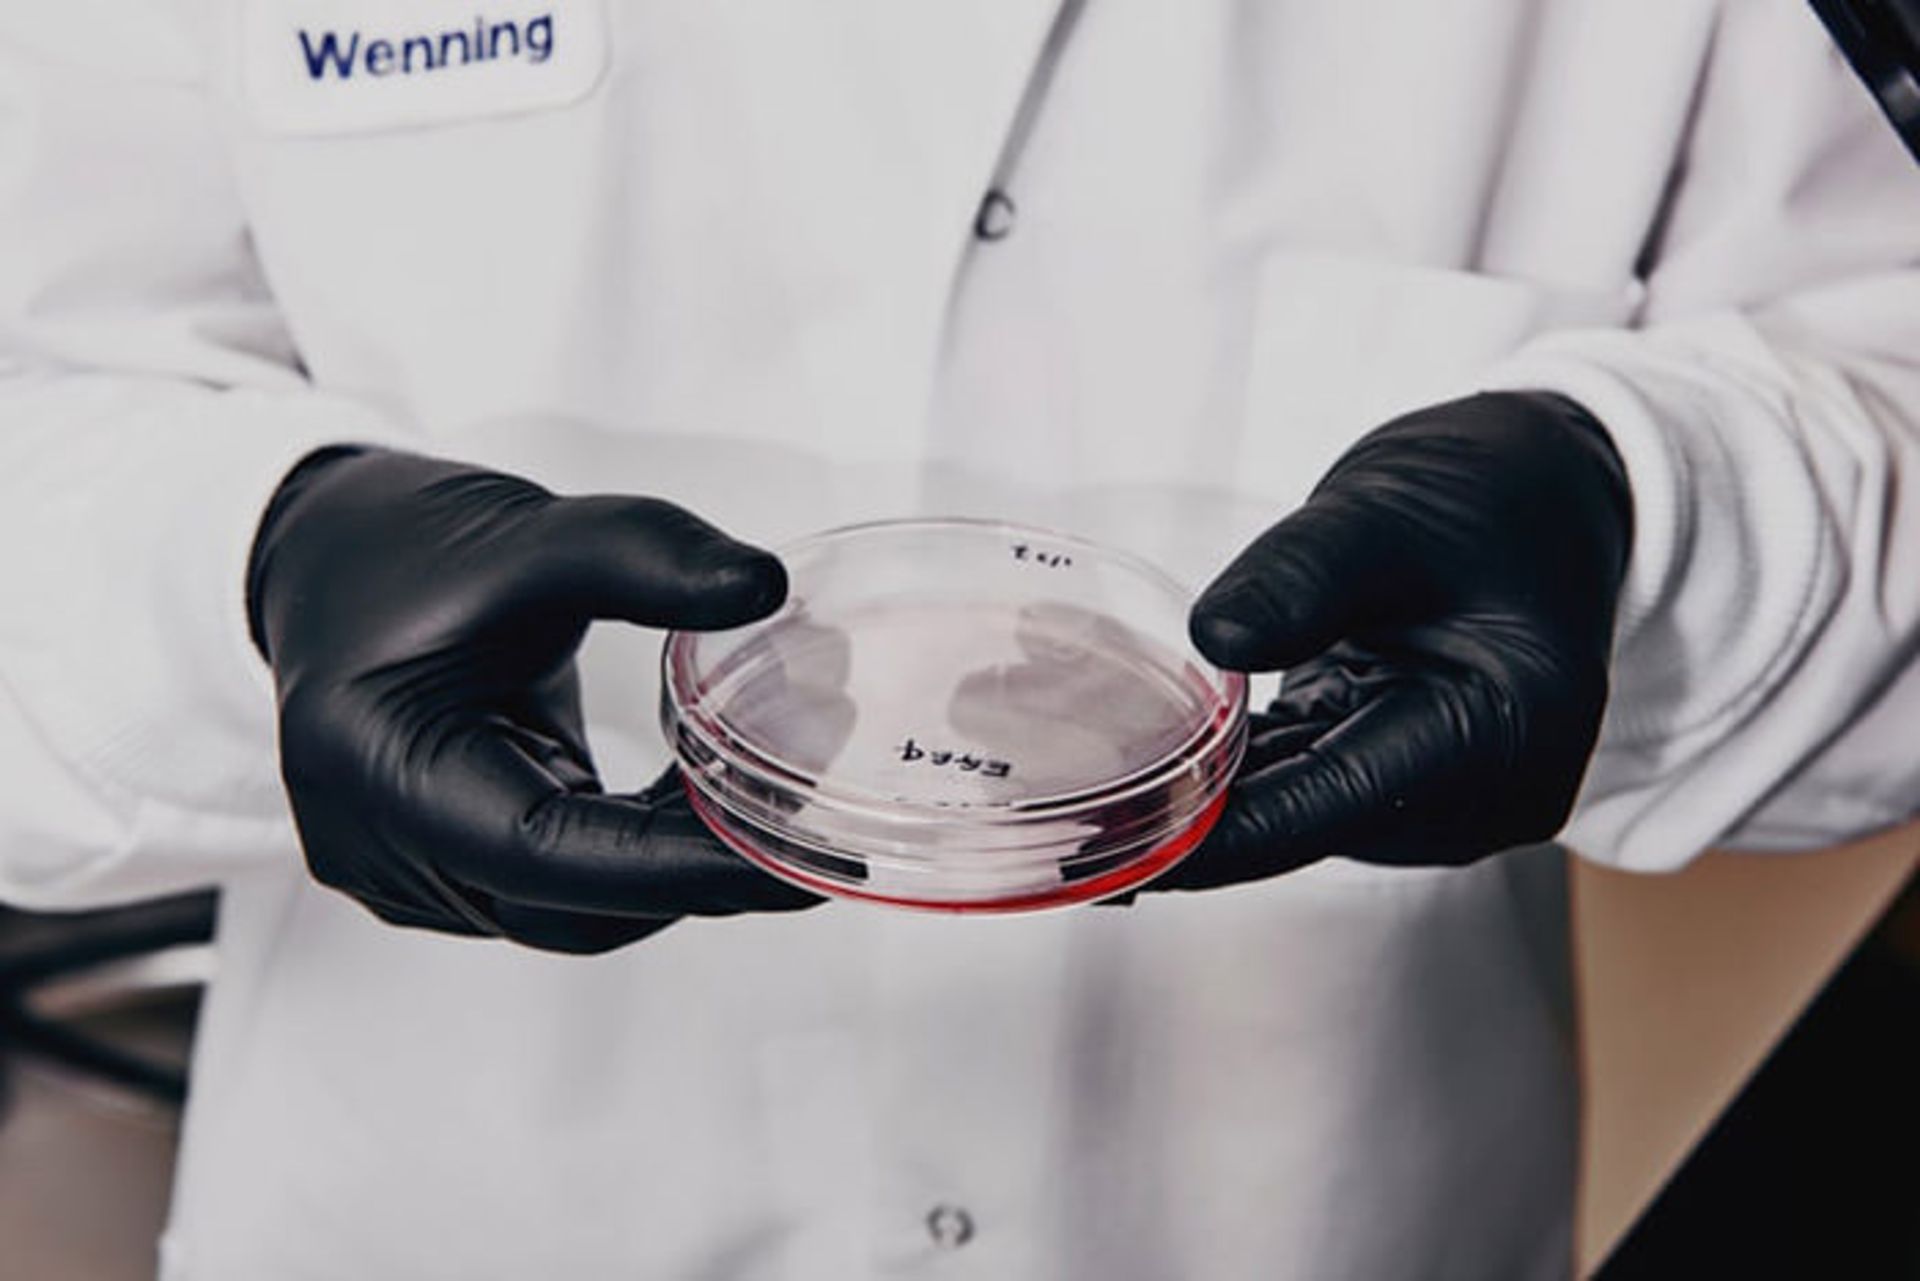
ویرایش ژنی

آیا پیوند عضو حیوان به انسان محقق خواهد شد؟

ونینگ کین درحالیکه ظرف آزمایشگاهی را در دست دارد، بادقت مایع صورتیرنگ داخل آن را بررسی میکند. او میگوید این سلولها از گوش خوک گرفته شدهاند و ممکن است بتوانند آیندهی پیوند عضو حیوان به انسان را متحول کنند. براساس پیشبینیها، پژوهشگرها در کرهجنوبی طی یک سال میتوانند قرنیهی خوک را به قرنیهی انسان پیوند بزنند. گروههای پژوهشی ایالاتمتحده هم در طی چند سال آینده، روی آزمایشهای پیوند عضو خوک کار خواهند کرد.
برای مثال میتوان به گروه بیمارستان عمومی ماساچوست در بوستون اشاره کرد که کار روی پوست خوک را برای مراقبت موقت پوستی قربانیان سوختگی آغاز کردهاند. پژوهشگرهای دانشکدهی پزشکی بیرمنگام (UAB) دانشگاه آلاباما، هم بهدنبال پیوند کلیهی خوک به افراد بزرگسال و پیوند قلب خوک به نوزادان تازه متولدشده هستند.

ووینگ کین، رئیس مهندسی ژنوم آزمایشگاه فرهنگ سلولی، در حال بررسی سلولهای خوک زیر میکروسکوپ در آزمایشگاه خود
دانشمندان مانند کین در استارتاپی بهنام eGenesis (ای جنسیس، در کمبریج ماساچوست) در حال کار روی ویرایش ژنی سلولهای خوک هستند. هدف آنها (که با هدف بسیاری از شرکتهای بیوفناوری ایالاتمتحده و اروپایی مهندس ژنتیکی مشترک است) تولید خوک برای پیوند ایمن عضو به انسان است. بهگفتهی ویلیام وستلین:
حالا ما در مرحلهای جادویی از پیوند عضو به سر میبریم. دیگر بحث امکانپذیری این کار مطرح نیست، بلکه بحث زمان آن مطرح است و اینکه چه زمانی عملی خواهد شد.
به عقیدهی ویلیام وستلین، معاون اجرایی پژوهش و توسعهی جنسیس، پژوهشهای پیوند عضو حیوان به انسان در مرحلهی طلایی قرار دارد
علم پیشرو
مدتها است که دانشمندان رویای نجات زندگی افراد ازطریق پیوند اعضای بدن حیوانات را در سر میپرورانند. نام دیگر این فرایند xenotransplantation (پیوند عضو از حیوان به انسان) است.
بااینکه در ابتدا بسیاری این فرایند را غیرممکن میدانستند، اما براساس آزمایشهای اولیه، تنها پس از پنج دقیقه بدن میتواند اعضای دریافتی را رد کند. بهگفتهی لئو بولهر، رئیس انجمن پیوند عضو بینالمللی، قبلا کسی جرأت نمیکرد حتی در مورد آزمایشهای پیوند عضو حیوان به انسان صحبت کند.
برای پیوند موفقیتآمیز کلیه، قلب یا ریهی خوک به انسان، باید سیستم ایمنی بدن انسان را فریب داد بهطوریکه تشخیص ندهد عضو دریافتی از گونهی غیرانسانی است. اینجا است که فناوری ویرایش ژن کریسپر وارد میشود و به دانشمندان امکان تغییر یک مجموعه از ژنها را بهصورت همزمان میدهد.
ای جنسیس از کریسپر (کوتاه شدهی تناوبهای کوتاه فاصلهدار و منظم خوشهای) برای حذف گروهی از ویروسهای نگرانکنندهی ژنوم خوک استفاده میکند. در مرحلهی بعدی، شاخصههای بیگانه برای سلولها حذف میشوند و درنتیجه سیستم ایمنی بدن انسان، عضو را میپذیرد.

کین در آزمایشگاه ای جنسیس
فاز آزمایشگاهی
در پژوهشی دیگر، دانشمندان به تست اعضای خوک (که قبلا دستکاری شده بودند) در نخستیسانان غیرانسانی (دستهای از پستانداران شامل تمام میمونها و کپیها) پرداختند. این مرحله گام مهمی در جهت آزمایشهای پزشکی روی انسان بود. براساس پژوهش جدید مجلهی Nature، چند نمونه بابون (گونهای میمون دم کوتاه) با قلب پیوندی خوک به مدت ۶ ماه زنده ماندند.
البته قبل از آن فرایند دستکاری ژنی روی قلب با هدف جلوگیری از عدم پذیرش عضو انجام شده بود. طولانیترین زمان پذیرش قلب در حیوانات به عضو پیوندی گونههای دیگر وابسته است. در مقالهای دیگر که اواخر ۲۰۱۷ منتشر شد، پژوهشگرهای مؤسسهی ملی سلامت ثابت کردند بابونها با قلب پیوندی خوک میتوانند تا سه سال زنده بمانند. بهگفتهی جای فیشمن، متخصص ایمنیشناسی و بیماریهای ویروسی بیمارستان عمومی ماساچوست، پیشرفت داروهای سرکوب ایمنی هم تا اندازهای عدم پذیرش عضو را کاهش داده است.
فعالان حقوق حیوانات با پژوهش روی نخستیسانان مخالفاند و چنین پژوهشهایی تنها تحت شرایط و امکانات محدود قابل انجام هستند. از طرفی بهگفتهی پژوهشگرها، انجام چنین پیوندهایی روی انسان بدون تست آنها روی نخستیسانان میتواند پرخطر باشد. سیستم ایمنی نخستیسانان با سیستم ایمنی انسان متفاوت است؛ بااینحال انجام تست روی بابونها هم چالشبرانگیز است.
البته، هیچ مانع علمی بزرگی برای پیوند عضو حیوان به انسان وجود ندارد و به اعتقاد برونو ریچرت، جراح قلب و پژوهشگر ارشد مقالهی Nature، اعضای بدن خوک هم میتوانند زندگی افراد را تضمین کنند. ریچرت سرپرست مرکز پژوهشی مشارکتی پیوند حیوان به انسان در بیمارستان دانشگاه مونیخ است.
او با هدف ضمانت زندگی تا ۶۰ درصد و حتی بیشتر از آن، روی پیوند قلب خوک کار میکند. هدف فعلی او، ضمانت زندگی برای حداقل یک سال است؛ اما استفاده از بابون و آموزش آن برای آزمایشهای روزانهی بازدارندهی ایمنی، کار سادهای نیست و انجام درمان وریدی طولانیمدت هم روی یک حیوان منطقی نیست.

ورقههای ایمونوهیستوشیمی (فرایند یافتن آنتیژنها در سلولهای بافت) کلیهی خوک در آزمایشگاه زیست مولکولی eGenesis
امکانات نامحدود
ظرفیت این فناوری گسترده است. در حال حاضر، ۷۵ هزار نفر در ایالاتمتحده در صف انتظار پیوند عضو قرار دارند. این در حالی است که روزانه ۲۰ نفر بهدلیل کمبود عضو میمیرند. ۶۰۰۰ نفر دیگر هم در بریتانیا در انتظار پیوند عضو هستند. برخلاف پیوند عضو از انسان که بیمار برای دریافت عضو باید منتظر مرگ شخص موردنظر بماند، میتوان بهصورت نامحدود از اعضا و سلولهای بدن خوک استفاده کرد.
دیون اکوف، جراح پیوند کبد میگوید اگر همین امروز انجام این پروژه مجاز شود، میتواند در طی ۹ ماه ۵۰ خوک با هدف پیوند تولید کند (فرایند دستکاری ژنتیکی روی این حیوانات انجام میشود و برای پیوند آماده میشود، ورود این حیوانات به صنعت غذا مجاز نیست بنابراین هیچ خطری برای عموم مردم ندارند). ایکوف میگوید:
دیدن بیمارانی که در صف پیوند عضو جان خود را از دست میدهند، ناامیدکننده و غمانگیز است. من زندگی خود را وقف پیوند کردم. تصور کنید با پیوند اعضای خوک چند نفر میتوانند زنده بمانند.

صفحات ایمونوهیستوشیمی کلیهی خوک در آزمایشگاه زیست مولکولی ای جنسین
فایدهی چنین خوکهایی بسیار فراتر از پیوند اعضا است. از این خوکها میتوان برای تولید سلولهای ایسلت (خوشه سلولهای هورمونساز لوزالمعده) موردنیاز مبتلایان به دیابت استفاده کرد. از خون خوکهای دستکاریشده میتوان برای تزریق خون به بیماران مبتلا به آسیبها و بیماریهای مزمن مثل کمخونی سلولی استفاده کرد. بهگفتهی دیوید کوپر، یکی از مدیران برنامهی پیوند حیوان به انسان در UAB، حتی میتوان از خوکها به تولید سلولهای دوپامینساز رسید و آنها را به بیماران مبتلا به پارکینسون پیوند زد. کوپر میگوید:
این کشف، علم پزشکی را متحول خواهد کرد. بهزودی دسترسی به اعضای پیوندی آسانتر از گذشته خواهد شد. اگر کسی دچار حملهی قلبی شود، میتوان قلب خوک را سریعا به او پیوند زد. این کشف، ظرفیت بسیار بالایی دارد.
حتی اگر عضو پیوندی خوک تا ابد دوام نیاورد، میتواند برای شخص زمان بخرد. بهگفتهی دیوید کلولاند، جراح قلب UAB، در حال حاضر نوزادان تازهمتولدشده بیش از سه ماه در صف انتظار قلب جدید قرار میگیرند و درنتیجه نرخ مرگومیر آنها بیش از ۵۰ درصد است.

ای جنسیس، شرکت فناوری زیستی که با روش کریسپر اعضای خوکهای دستکاریشدهی ژنتیکی را به انسان پیوند میزند
هدف کلولاند، پیوند عضو حیوان به انسان برای نجات جان نوزادان مبتلا به نارسایی قلبی است. بزرگسالهایی که در صف پیوند قرار دارند، میتوانند با قلب مصنوعی جان خود را نجات دهند اما چنین دستگاهی برای نوزادان وجود ندارد. البته مشکلات زیادی در پیوند دائمی قلب خوک به نوزاد وجود دارد اما حداقل میتوان از قلب خوک بهعنوان پلی موقتی برای زنده نگهداشتن بیمار تا زمان دسترسی او به قلب انسانی، استفاده کرد. از طرفی سیستم ایمنی ناقص کودکان، عمل پیوند قلب خوک را آسانتر میسازد.
از قلب خوک میتوان برای درمان مبتلایان به نارسایی قلبی استفاده کرد
بهگفتهی جرمی گاورمن، پژوهشگر ارشد آزمایشهای پوستی ماساچوست، از پوست خوک میتوان برای جایگزینی پوستهای سوخته استفاده کرد. به عقیدهی او، بخشهای پوست انسان وسعت کافی را برای پوشش زخمهای بزرگ ندارند. نمونهبرداری از پوست خوک ازنظر هزینه بهینهتر از پوست مرده است. پوست خوک برای کشورهایی که توانایی نگهداری بانکهای بافت پوست را ندارند، میتواند بهعنوان جایگزینی برای نجات جان انسانها به کار برود.
آیندهی پژوهش
هدف پژوهشگرهای UAB در سال جاری، پرورش حیوانات بیشتر به این روش است. برنامهی آنها پرورش حیواناتی به وزن ۶۸ کیلوگرم برای آزمایشهای پزشکی کوچک روی افراد است؛ اما مثل همیشه، هزینه مشکلساز است. از طرفی پژوهشگرها نسبت به افکار عمومی در مورد پیوند انسان به حیوان هم نگراناند. اگرچه، براساس رأیگیریهای اولیه، مردم نسبت به این فناوری خوشبین هستند. البته بعضی گروهها هم با قربانیکردن حیوانات برای آزمایش و پیوند عضو مخالفاند، حتی اگر کشتن حیوانات به قیمت نجات زندگی انسان تمام شود.

سلولهای دستکاریشدهی خوک زیر میکروسکوپ در شرکت ای جنسیس
پژوهشگرها بهدلیل واهمه از فعالان حقوق حیوانات، موقعیت آزمایشگاههای پژوهشی خود را فاش نمیکنند؛ اما کوپر میگوید آمریکاییها سالانه ۱۲۰ میلیون خوک میخورند و پیوند حیوان به انسان در آیندهای نزدیک فراگیر خواهد شد.
او معتقد است بیماران ناامید از درمان، از دریافت عضو خوک رضایت خواهند داشت. کوپر معتقد است نگرش افراد در حال مرگ، به این مسئله متفاوت خواهد بود. بهگفتهی فیشرمن، آخرین مانع این پروژه، تست آن روی افراد است و همه بیصبرانه منتظر اولین آزمایش پزشکی این پروژه روی انسان هستند.